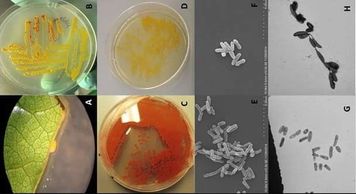

OBJECTIVE :
TOPICS :

OBJECTIVE :
TOPICS :

OBJECTIVE :
TOPICS :

OBJECTIVE :
TOPICS :

OBJECTIVE :
TOPICS :
OBJECTIVE :
TOPICS :

OBJECTIVE :
TOPICS :

OBJECTIVE :
TOPICS :

OBJECTIVE :
TOPICS :

OBJECTIVE :
TOPICS :

OBJECTIVE :
TOPICS :

OBJECTIVE :
TOPICS :

OBJECTIVE :
TOPICS :

OBJECTIVE :
TOPICS :

OBJECTIVE :
TOPICS :

OBJECTIVE :
TOPICS :

OBJECTIVE :
TOPICS :

OBJECTIVE :
TOPICS :

OBJECTIVE :
TOPICS :

OBJECTIVE :
TOPICS :
Copyright © 2012-2026 DPG-VeC. Genetics & Life Science, SC (LLP). All rights reserved.
(Tax ID - RUC▪180511-9729 | FŔ.-9838/13)

Backlog filings with docket submission will be reviewed from 2Pm to 4Pm (CST/UTC-6) i.e. 2nd to 8th day of every month. Platform - V.C for executives (only sanctioned leave) & in-person presence required in Board Meeting Hall for executives, HODs, researchers, staffs and interns.
-PI Head Custodian, BSL-2P
This website uses cookies. By continuing to use this site, you accept our use of cookies.